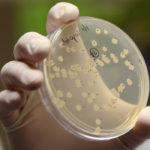

Tag Archives COVID-19 virus

COVID changes consumer attitudes

Bibeau repeats plea to farmers to use existing BRM funds
Agriculture minister says it is difficult for her to obtain more government money if programs are not already accessed
Canada’s agriculture minister is asking farmers to help her to get more support money for them. To do that, they’ll need to use the money already in their business risk management accounts and show where it isn’t adequate, she warns. “If they are not accessing the programs that are available to them, it’s harder for […] Read more
Ag Canada field research may drop to 30 percent

Expecting more from gov’t a mistake

More slaughter plants not the answer: Unrau
Former CCA leader has changed his mind about the benefits of increasing the number of packing facilities on the Prairies
About 15 years ago, Martin Unrau assumed that small slaughter plants made sense. If Western Canada had a number of beef processing plants scattered across the Prairies, they could benefit cattle producers and the beef industry. Then he became president of the Manitoba Cattle Producers Association and the Canadian Cattlemen’s Association, and that completely changed […] Read more
Sask. aids cattle producers as backlog builds
Sector welcomes province’s decision to contribute to AgriRecovery funding and offset livestock insurance premium costs
Saskatchewan cattle producers say provincial funding announced May 14 will help them through uncertain COVID-19 markets, but the real fix would be a return to full slaughter capacity. Agriculture minister David Marit said the Saskatchewan government will contribute $5 million, or its 40-percent share, to the AgriRecovery program that Ottawa announced May 5. He also […] Read more
Auctions hold on through slowdown
Markets say cattle sales continue despite physical distancing measures and a slight drop in sales volume
It’s a surreal sight for auctioneer Rob Bergevin as he takes bids for cattle at Foothills Auctioneers in Stavely, Alta. He looks out at the tiered wooden stands that hold a maximum of 15 people, each sitting far apart. The public health restrictions on crowds and distancing make it so, but it’s a far cry […] Read more
New industrial policy urged

Is North America’s food supply system a disaster or a success story?
Under the stress of COVID-19 both the flaws and resiliency of the Canadian and U.S. food systems have become popular topics
